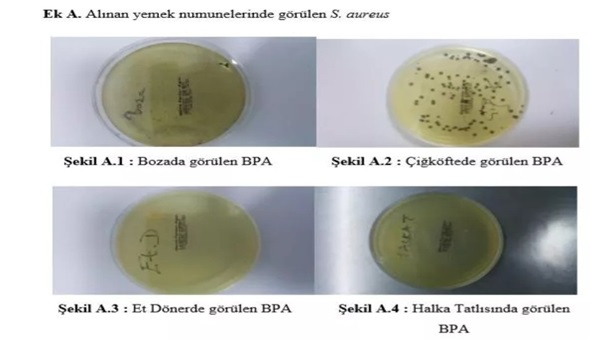
Sokaktan aldığınız bakteriler böyle görüntülendi!

İstanbul'da yapılan araştırma, sokak lezzetlerinin tüketiminden doğacak mikrobiyolojik riskleri ortaya çıkardı. Test edilen yiyeceklerin yüzde 65'inde "Staphylococcus Aureus", yüzde 25'inde "E.coli", yüzde 10'unda "Salmonella" gibi patojen bakteriler tespit edildi.
YİYECEKLERİN YÜZDE 65'İNDE GIDA ZEHİRLENMESİ RİSKİ
Doğan, "Sokak yemeklerinin gıda güvenliği açısından değerlendirilmesiyle ilgili Türkiye'de ilk olan bir araştırma yaptık. Yiyeceklerden aldığımız numunelerinin yüzde 65'inde 'Staphylococcus Aureus' çıktı. Bu mikroorganizma özellikle gıda zehirlenmelerine neden oluyor" diye konuştu.
HER 4 YİYECEKTEN 1'İNDE E.COLİ BAKTERİSİ BULUNUYOR
Araştırılan numunelerde her 4 yiyecekten 1'nde 'E.coli' bakterisinin bulunduğunu söyleyen Doğan, "Bu da dışkı kaynaklı, halk sağlığını büyük şekilde tehdit eden bir unsur. Sokak yemeklerinde gıda güvenliği açısından büyük problem yaşanıyor. Bu durum bir an önce kontrol altına alınmalı" ifadelerini kullandı. E.Coli bakterisinin bulunduğu yiyecekler arasında; tavuk döner, tavuklu pilav, Arnavut ciğeri, soğuk sandviç ve karışık tost bulunuyor.İşte yiyeceklerin ve sokakta çalışanların elinden alınan örneklerden üreyen patojenlerin görüntüsü:
.jpg)

Hayrettin Ulusoy 96 yaşında vefat etti
Hayrettin Ulusoy 96 yaşında vefat etti
 Parti sayısı patladı!
Parti sayısı patladı!
 Bu ne hal gençler!
Bu ne hal gençler!




